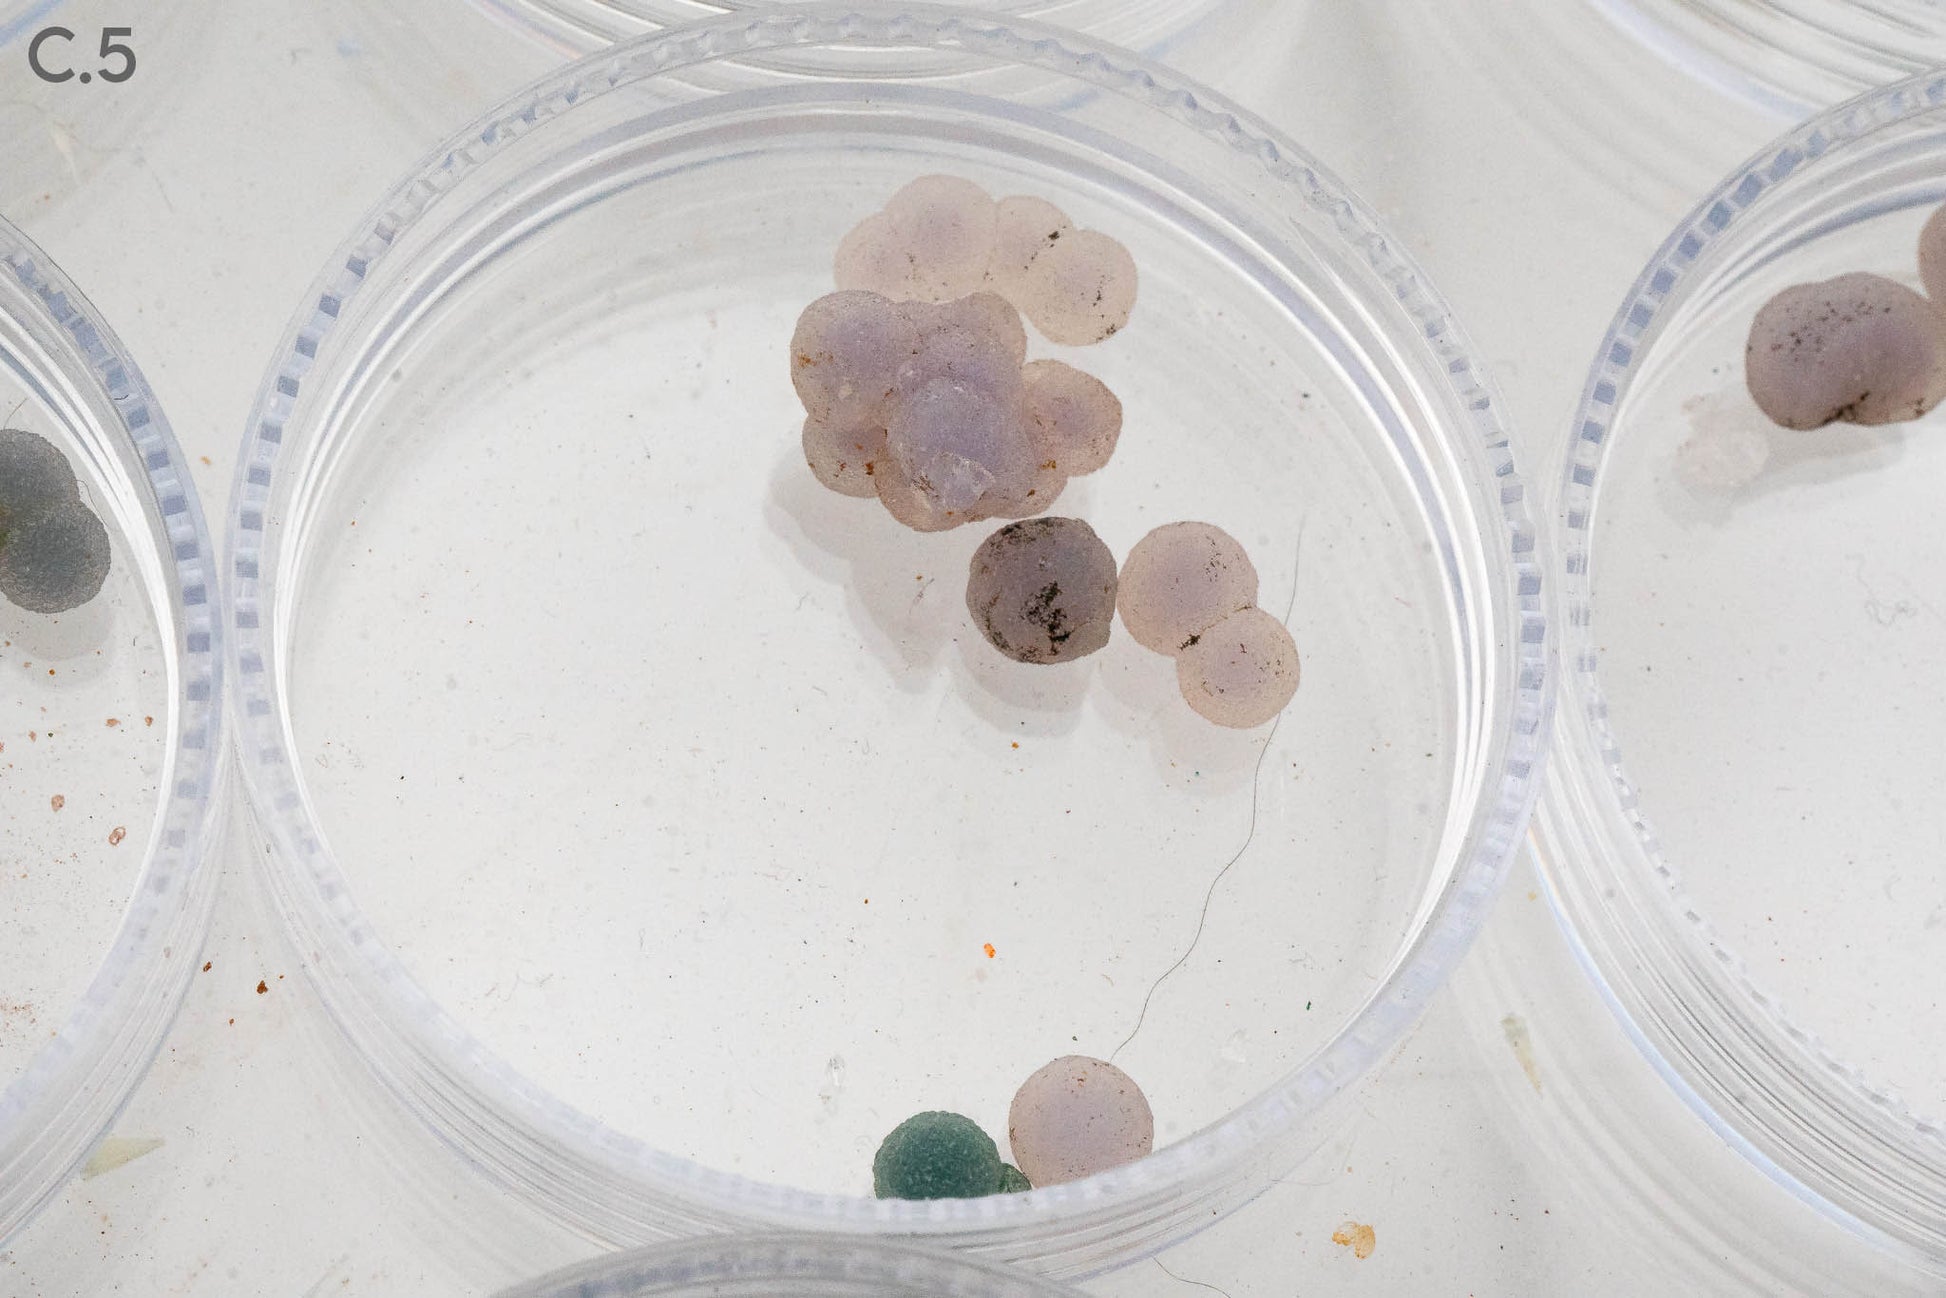

Explore a hand-selected collection of distinctive
crystals, minerals, and natural specimens from
around the world.

Fossil


Fossil